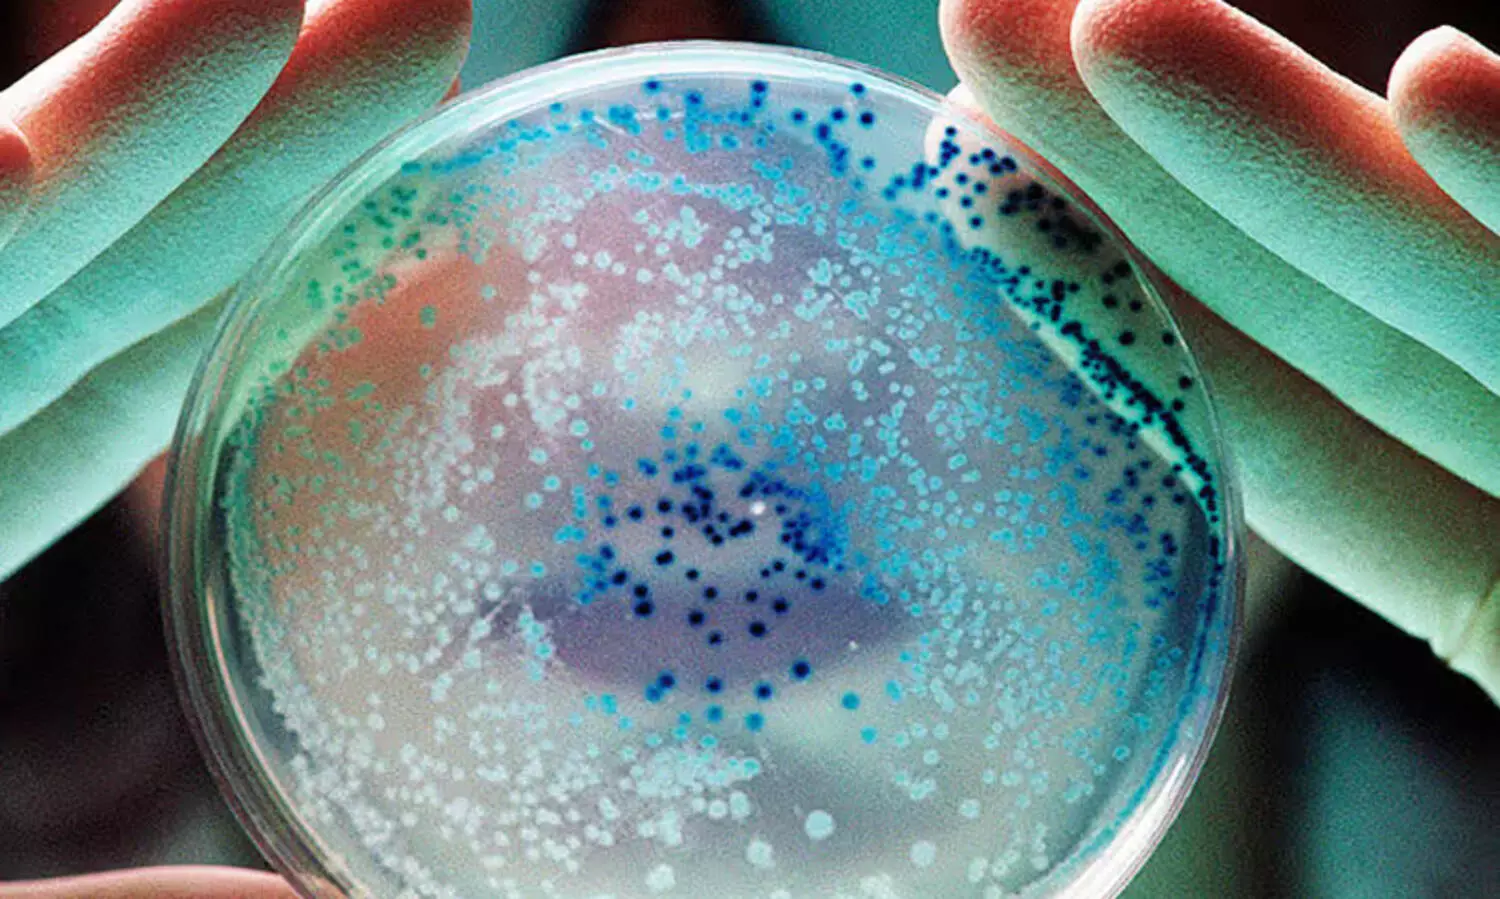
തലവടിയിലെ രഘുവിന്‍റെ മരണം കോളറയല്ല;   കുട്ടനാട്ടിൽ ആരോഗ്യവകുപ്പ്​ ജാഗ്രതനിർദേശം തുടരും

ARCHIVE SiteMap 2025-05-17
 കണ്ണൂരും കോഴിക്കോടും ലോകായുക്ത ക്യാമ്പ് സിറ്റിംഗ് നടത്തും
കണ്ണൂരും കോഴിക്കോടും ലോകായുക്ത ക്യാമ്പ് സിറ്റിംഗ് നടത്തും തലവടിയിലെ രഘുവിന്റെ മരണം കോളറയല്ല; കുട്ടനാട്ടിൽ ആരോഗ്യവകുപ്പ് ജാഗ്രതനിർദേശം തുടരും
തലവടിയിലെ രഘുവിന്റെ മരണം കോളറയല്ല; കുട്ടനാട്ടിൽ ആരോഗ്യവകുപ്പ് ജാഗ്രതനിർദേശം തുടരും തിരുവാഭരണ മോഷണം: ശാന്തിക്കാരൻ അറസ്റ്റിൽ; ജ്വല്ലറിയിൽ വിൽപന നടത്തിയ സ്വർണം പൊലീസ് കണ്ടെടുത്തു
തിരുവാഭരണ മോഷണം: ശാന്തിക്കാരൻ അറസ്റ്റിൽ; ജ്വല്ലറിയിൽ വിൽപന നടത്തിയ സ്വർണം പൊലീസ് കണ്ടെടുത്തു ഓൺലൈനിലൂടെ പരിചയപ്പെട്ട പാസ്റ്ററെ കാണാൻ അതിർത്തി കടന്ന് പാകിസ്താനിലെത്തിയ ഇന്ത്യൻ യുവതി കസ്റ്റഡിയിൽ
ഓൺലൈനിലൂടെ പരിചയപ്പെട്ട പാസ്റ്ററെ കാണാൻ അതിർത്തി കടന്ന് പാകിസ്താനിലെത്തിയ ഇന്ത്യൻ യുവതി കസ്റ്റഡിയിൽ ഓൺലൈനിലൂടെ പരിചയപ്പെട്ട പാസ്റ്ററെ കാണാൻ അതിർത്തി കടന്ന് പാകിസ്താനലെത്തിയ ഇന്ത്യൻ യുവതി കസ്റ്റഡിയിൽ
ഓൺലൈനിലൂടെ പരിചയപ്പെട്ട പാസ്റ്ററെ കാണാൻ അതിർത്തി കടന്ന് പാകിസ്താനലെത്തിയ ഇന്ത്യൻ യുവതി കസ്റ്റഡിയിൽ കണ്ണുനിറഞ്ഞ് രോഹിത്തിന്റെ രക്ഷിതാക്കൾ, പിന്നിലേക്ക് നീങ്ങി കണ്ണ് തുടച്ച് ഭാര്യ റിതിക; വാംഖഡെയിൽ വൈകാരിക നിമിഷങ്ങൾ -വിഡിയോ
കണ്ണുനിറഞ്ഞ് രോഹിത്തിന്റെ രക്ഷിതാക്കൾ, പിന്നിലേക്ക് നീങ്ങി കണ്ണ് തുടച്ച് ഭാര്യ റിതിക; വാംഖഡെയിൽ വൈകാരിക നിമിഷങ്ങൾ -വിഡിയോ റോഹിങ്ക്യൻ അഭയാർഥികളെ നാവികസേന കടലിലേക്ക് തള്ളിയിട്ടോ?
റോഹിങ്ക്യൻ അഭയാർഥികളെ നാവികസേന കടലിലേക്ക് തള്ളിയിട്ടോ? കേരളത്തിൽ ആയിരത്തിലധികം അയോഗ്യരായ അഭിഭാഷകർ!
കേരളത്തിൽ ആയിരത്തിലധികം അയോഗ്യരായ അഭിഭാഷകർ! നീരജിന്റെ ഭാഗ്യദോഹ; ഡയമണ്ട് ലീഗിൽ തിളങ്ങി ഇന്ത്യയുടെ സൂപ്പർതാരം; 90.23 മീറ്ററുമായി ചരിത്രനേട്ടം
നീരജിന്റെ ഭാഗ്യദോഹ; ഡയമണ്ട് ലീഗിൽ തിളങ്ങി ഇന്ത്യയുടെ സൂപ്പർതാരം; 90.23 മീറ്ററുമായി ചരിത്രനേട്ടം ഹജ്ജിന് പോയ ദമ്പതികളുടെ വീട്ടിൽ മോഷണശ്രമം; കള്ളൻറെ കണ്ണിൽപ്പെടാത്തതുകൊണ്ട് 25 പവൻ തിരിച്ചുകിട്ടി
ഹജ്ജിന് പോയ ദമ്പതികളുടെ വീട്ടിൽ മോഷണശ്രമം; കള്ളൻറെ കണ്ണിൽപ്പെടാത്തതുകൊണ്ട് 25 പവൻ തിരിച്ചുകിട്ടി മുതലപ്പൊഴി മണൽ നീക്കം: റോഡ് ഉപരോധം സംഘർഷഭരിതം; അറസ്റ്റ്
മുതലപ്പൊഴി മണൽ നീക്കം: റോഡ് ഉപരോധം സംഘർഷഭരിതം; അറസ്റ്റ് ലുസൈലിൽ ഇനി ടി.ടി പോരാട്ടങ്ങൾ
ലുസൈലിൽ ഇനി ടി.ടി പോരാട്ടങ്ങൾ

